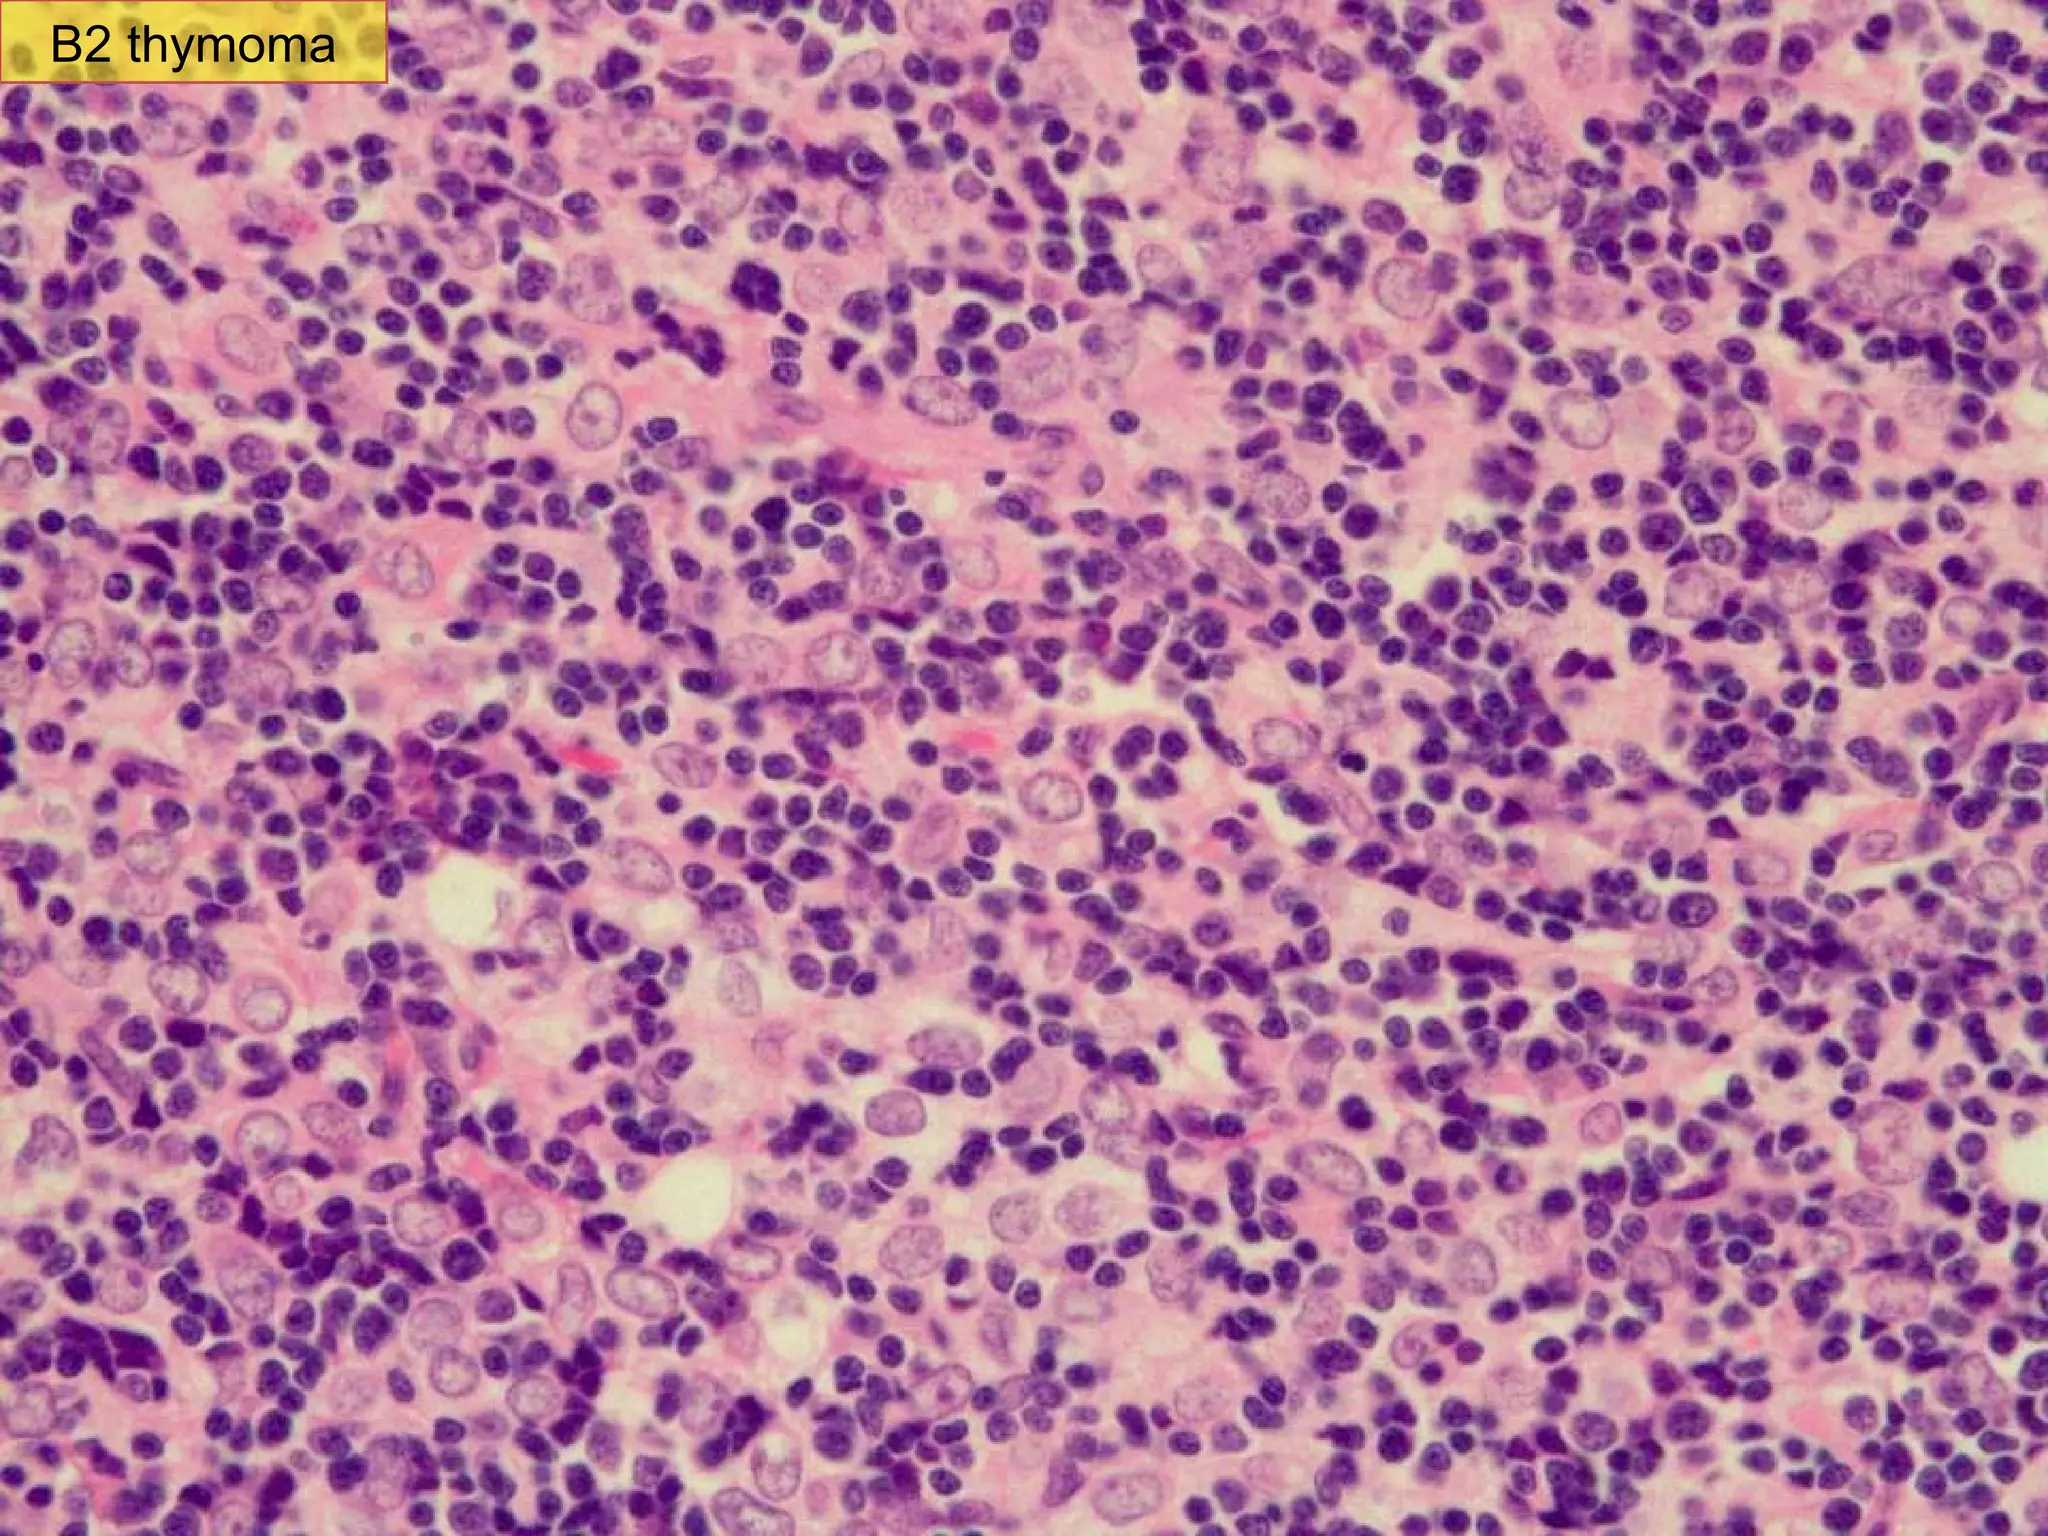
B2 thymoma area B2 thymoma

Embed presentation
Download as PPS, PPTX









A 47-year-old man underwent a chest CT that incidentally discovered a mediastinal mass. Upon examination, doctors found that the man had a B2 thymoma, a type of thymus tumor, that contained squamous cell carcinoma. The squamous cell carcinoma had arisen within the pre-existing B2 thymoma.